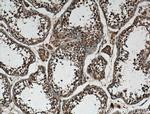
P3H1 Antibody in Immunohistochemistry (Paraffin) (IHC (P))

Search
Proteintech
P3H1 Polyclonal Antibody
{{$productOrderCtrl.translations['antibody.pdp.commerceCard.promotion.promotions']}}
{{$productOrderCtrl.translations['antibody.pdp.commerceCard.promotion.viewpromo']}}
{{$productOrderCtrl.translations['antibody.pdp.commerceCard.promotion.promocode']}}: {{promo.promoCode}} {{promo.promoTitle}} {{promo.promoDescription}}. {{$productOrderCtrl.translations['antibody.pdp.commerceCard.promotion.learnmore']}}
产品信息
26691-1-AP
种属反应
宿主/亚型
分类
类型
抗原
偶联物
形式
浓度
规格
纯化类型
保存液
内含物
保存条件
运输条件
产品详细信息
Immunogen sequence: EVESEAGWG MVTPDLLFAE GTAAYARGDW PGVVLSMERA LRSRAALRAL RLRCRTQCAA DFPWELDPDW SPSPAQASGA AALRDLSF (23-109 aa encoded by BC108311 )
靶标信息
Basement membrane-associated chondroitin sulfate proteoglycan (CSPG). Has prolyl 3-hydroxylase activity catalyzing the post-translational formation of 3-hydroxyproline in -Xaa-Pro- Gly- sequences in collagens, especially types IV and V. May be involved in the secretory pathway of cells. Has growth suppressive activity in fibroblasts.
仅用于科研。不用于诊断过程。未经明确授权不得转售。
生物信息学
蛋白别名: Growth suppressor 1; leprecan; Leprecan-1; leucine proline-enriched proteoglycan (leprecan) 1; Leucine- and proline-enriched proteoglycan 1; procollagen-proline 3-dioxygenase; Prolyl 3-hydroxylase 1; unnamed protein product
基因别名: GROS1; LEPRE1; OI8; P3H1; PSEC0109
UniProt ID: (Human) Q32P28
Entrez Gene ID: (Human) 64175